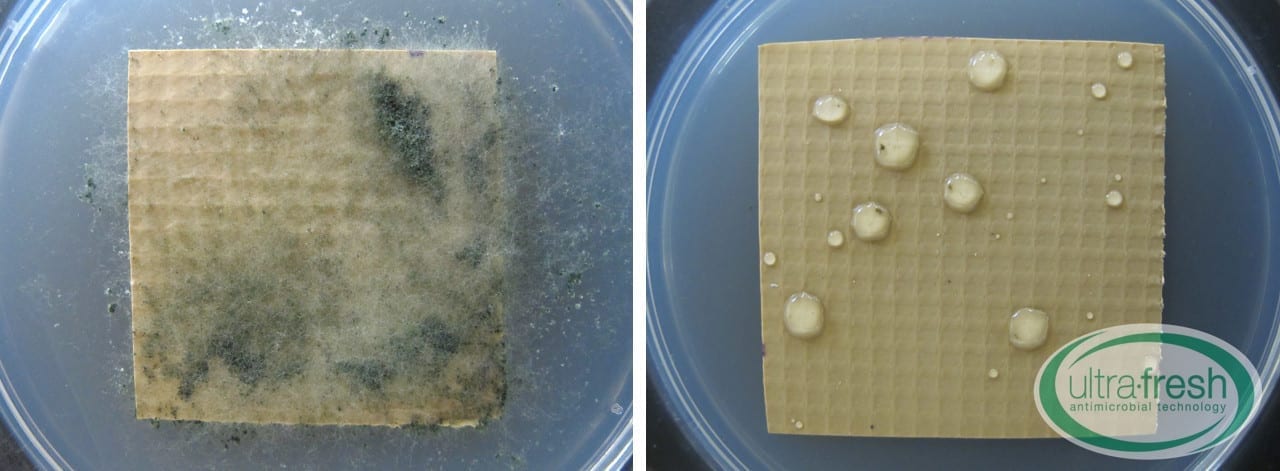
ASTM G21 Untreated vs Treated Test Specimens

For a free ASTM G21 summary download, please keep scrolling.
Standard Practice for Determining Resistance of Synthetic Polymeric Materials to Fungi
The ASTM G21 is a qualitative test that employs a high concentration of spores, from five different fungal species, to determine the resistance of synthetic polymeric materials to fungal growth.
Background on the ASTM G21 Test Method
Fungi are generally not able to break down the main resin component of synthetic polymer to use as a source of carbon (sugar). However, many additives, such as plasticizers, cellulose, lubricants, stabilizers, and colorants that are added to impart desirable characteristics, are very susceptible to microbial growth.
Once fungi become established by breaking down the easily digested ingredients, the acids they produce as by-products of growth break down the resin into a more useable food source.
A good analogy is how lighter fluid is used to successfully set charcoal on fire. The additives act as a quick burst of energy that unlocks the stored power in the polymer resin.
The ASTM G21 was first released in 1990 as an official method to test the resistance of synthetic polymers to fungal attack.
The current standard (ASTM G21-15) is the sixth version of this test method.
We often are asked for an ASTM G21 free download. Unfortunately, due to copyright laws, we cannot provide copies of the actual test method. However, the method can be downloaded directly from the ASTM for a relatively low cost. For a free download of our ASTM G21 PDF, please find it below, at the end of this webpage.
Previous versions of this test method are listed below:
Examples of polymers tested using the ASTM G21 include, but are not limited to, polyolefin's, such as polyethylene (PE) and polypropylene (PP), polyurethane (PU), vinyl/polyvinyl chloride (PVC), thermoplastic polyurethane (TPU), thermoplastic polyolefin (TPO), polyester (PES), acrylonitrile butadiene styrene (ABS), polycarbonate (PC), rubber, etc. They may be in the form of films, sheets, molded materials, coatings, foams, tubes, pipes, pucks, tiles, plaques, rods, etc.
Other materials, such as paint, drywall, cardboard, fibers, and adhesives may also be tested using the ASTM G21 method.
ASTM G21 Testing
Test samples are placed on an agar medium that is carbon-free (no readily available energy source) but contains the basic mineral salts required for fungi to grow. Having a carbon-free medium forces the fungi to grow on the test specimen and not on the surrounding agar surface.
ASTM G21 Fungi
After being placed on the mineral salts medium, the test sample is inoculated with a concentrated spore suspension (inoculum) that contains five different fungal species. Each ASTM G21 fungus recommended for use in the method is listed below:
- Aspergillus brasiliensis (formerly known as Aspergillus niger)
- Aureobasidium pullulans
- Chaetomium globosum
- Trichoderma virens (formerly known as Gliocladium virens)
- Penicillium funiculosum (formerly known as Penicillium pinophilum)
[caption id="attachment_3325" align="aligncenter" width="600"]

Aspergillus brasiliensis (formerly Aspergillus niger)
[caption id="attachment_3328" align="aligncenter" width="600"]

Aureobasidium pullulans
[caption id="attachment_3331" align="aligncenter" width="600"]

Chaetomium globosum
[caption id="attachment_3334" align="aligncenter" width="600"]

Penicillium funiculosum (formerly Penicillium pinophilum)
[caption id="attachment_3337" align="aligncenter" width="600"]

Trichoderma virens (formerly Gliocladium virens)
These fungi were chosen by the ASTM based on their affinity for using plasticizers, cellulose, lubricants, stabilizers, and colorants as food sources.
Test plates are incubated at 28C at 90% relative humidity for 28 days to allow any possible fungal growth to develop. The test samples are examined every seven days to monitor progress.
ASTM G21 Testing Assessment
The samples are examined under a dissecting microscope at 40x magnification. A rating score from 0 to 4 is given based on the amount of growth that exists. The description of the rating system is as follows:
0 = Specimen remained free of fungal growth.
1 = Traces of growth on the specimen (less than 10%).
2 = Light fungal growth on the specimen (10 to 30%).
3 = Medium fungal growth on the specimen (30 to 60%).
4 = Heavy fungal growth on the specimen (60% to complete coverage)
The method does not outline the pass/fail criteria. However, the test method may be terminated earlier for specimens that are experiencing a rating of “2” or higher.
The untreated vinyl sample supports heavy amounts of fungal growth (rating of "4"). The vinyl sample, treated with an antimicrobial agent, remains free of fungal growth (rating of "0") after 28 days of incubation, as per the test specifications.
Size of Test Specimens
The desired test specimen size is a 50 mm/2-inch square, 50 mm/2-inch diameter circle or a piece that is at least 76 mm/3-inches in length. Before submitting samples for the first time, contact your chosen test lab for more information and guidance.
Strengths and Weaknesses of the Test Method
ASTM G21 Strengths:
- Since all the requirements for growth are present (minerals, temperature, humidity, high concentration of spores) except for a readily available energy source, the test specimen’s true capability of resisting fungal attack is evaluated.
- The ASTM G21 includes several fungi, selected from a broad range of environments. These fungal organisms have distinct nutrient preferences and utilize different enzymatic pathways. As a result, test samples are exposed to several different modes of attack while using one test method. Conversely, many other test methods utilize only one test organism. This reduces the number of possible ways a test sample can be attacked and may mask the sample's true potential susceptibility to fungal growth.
ASTM G21 Weaknesses:
- As the scoring guideline is quite subjective, the test results are susceptible to a wide range of interpretations. What may be assessed as 25% coverage (rating of “2”) by one technician, may easily be considered 35% coverage (rating of “3”) by another.
- The inoculum is prepared by using the five indicated fungal species grown separately on nutrient-rich agar plates. As the spores are harvested, an inexperienced technician may accidentally introduce trace amounts of nutrients into the freshly prepared inoculum, introducing the chance for fungal growth that otherwise may not occur.
- The incubation time is 28 days which can be quite long for manufacturers who are waiting to release goods or who want to begin manufacturing but are waiting for results from a trial. In a case where the test method is used as a screening tool, the customer may want to also explore or inquire about other tests such as the AATCC Method 30, Part III which has a shorter incubation time. Another option is to work with the lab to make appropriate modifications to the ASTM G21 method. Speak to a knowledgeable microbiology laboratory manager to discuss further.
- Some untreated materials do not support fungal growth after testing using the test method. However, these materials may be exposed to very high amounts of carbon/sugar during their useful life that does result in a fungal attack in a real-world scenario. Therefore, the sample’s true ability to withstand fungal attack may not be well reflected using the ASTM G21.
- Note: the method may be modified by including a nutrient source, as long as this variation is made clear in the final test report. It is important to discuss the end-use environment with the testing lab to ensure relevant test conditions are employed.
Cost to Test Samples Using the ASTM G21
The cost to test specimens using third-party laboratories varies widely from lab to lab.
In North America, there are test facilities that charge as low as $175 USD per sample and go up as high as $530 USD for the first sample ($340 USD for each additional sample).
ASTM G21 Free Download
As mentioned previously, we cannot provide copies of the actual test method. However, for those who do not require the official test method, please check out our ASTM G21 PDF for a comprehensive summary.
[pdf_button text="ASTM G21 Free Download" url="https://ultra-fresh.com/wp-con..." target="_blank"]
Where To Go Now?
Still, have questions? Contact us for more information.